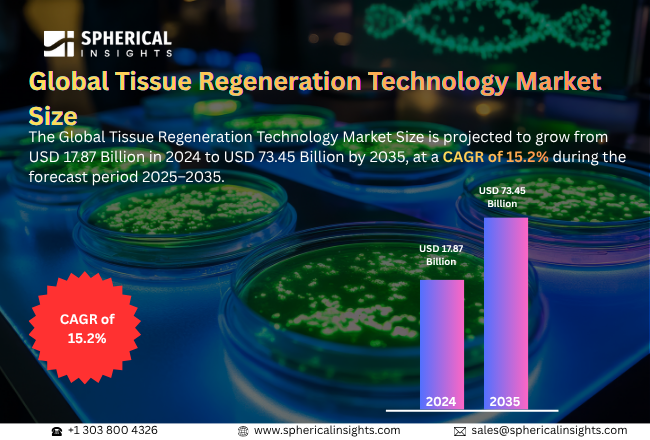
Tissue Regeneration Technology Market

Top 20 Companies in the Global Tissue Regeneration Technology Market (2025–2032): Spherical Insights Analysis
RELEASE DATE: Apr 2026 Author: Spherical InsightsRequest Free Sample Speak to Analyst
Description
According to a research report published by Spherical Insights & Consulting, The Global Tissue Regeneration Technology Market Size is projected to grow from USD 17.87 Billion in 2024 to USD 73.45 Billion by 2035, at a CAGR of 15.2% during the forecast period 2025–2035. Global market expansion is hindered in organ transplantation, surged in chronic diseases & ageing population, and technological advancements.
Introduction
The global tissue regeneration technology market is largely influenced by basic healthcare requirements and advancements in science rather than purely business considerations. The fact that the human body has a very poor natural regenerative capacity for certain tissues, like heart muscle, nerves, and cartilage, is a major driving force behind tissue regeneration technology. This is further compounded by a lack of donated tissues and the risks involved in transplant procedures, making tissue engineering a promising field. The World Health Organisation reports that worldwide organ demand remains unmet because less than 10% of the need receives fulfilment despite 173,000 transplants that occurred throughout the globe during 2024. Furthermore, an increase in lifestyle-related conditions like diabetes and heart disease, and a rise in the elderly population, are all factors that are propelling tissue repair treatments. There has also been considerable advancement in areas like stem cell biology and 3D printing that have made tissue regeneration more accessible. In addition, a change in healthcare policy from a reactive maintenance of symptoms to a more functional restoration of health is another factor that is propelling tissue regeneration technology. There is a rise in trauma and injury cases, and patients are more demanding of treatments that can restore their quality of life and improve their functional recovery.
Navigate Future Markets with Confidence: Insights from Spherical Insights LLP
The insights presented in this blog are derived from comprehensive market research conducted by Spherical Insights LLP, a trusted advisory partner to leading global enterprises. Backed by in-depth data analysis, expert forecasting, and industry-specific intelligence, our reports empower decision-makers to identify strategic growth opportunities in fast-evolving sectors. Clients seeking detailed market segmentation, competitive landscapes, regional outlooks, and future investment trends will find immense value in the full report. By leveraging our research, businesses can make informed decisions, gain a competitive edge, and stay ahead in the transition toward sustainable and profitable solutions.
Unlock exclusive market insights—Download the Brochure now and dive deeper into the future of the Tissue Regeneration Technology Market.
Tissue Regeneration Technology Market Size & Statistics
- The Market Size for Tissue Regeneration Technology Was Estimated to be worth USD 17.87 Billion in 2024.
- The Market Size is Going to Expand at a CAGR of 15.2% between 2025 and 2035.
- The Global Tissue Regeneration Technology Market Size is anticipated to reach USD 73.45 Billion by 2035.
- North America is estimated to dominate the market during the forecast period in the Tissue Regeneration Technology Market.
- Asia-Pacific is projected to grow the fastest during the forecast period in the Tissue Regeneration Technology Market.

Market Segmentation
Global Tissue Regeneration Technology Market Size, Share, By Technology (Cell Therapy, Stem Cell Therapy, Stem Cell Sources, and Others), By Raw Material (Synthetic, Genetically modified, and Biological), By Application (Cardiovascular, Oncology, Dermatology, Orthopedic, Neurology, and Others), and By Region (North America, Europe, Asia-Pacific, Latin America, Middle East, and Africa), Analysis and Forecast 2025 – 2035.
Regional growth and demand
North America is expected to dominate the market during the forecast period in the tissue regeneration technology market.
North America held the majority of the market share by revenue for the tissue regeneration technology market. North America leads the tissue regeneration technology market because its advanced healthcare facilities, high healthcare spending, and major pharmaceutical and biotech companies create an advantageous environment. The market receives support through research funding, the initial adoption of regenerative medicine, and the high prevalence of chronic diseases. The United States faces a severe organ donor shortage because more than 104000 patients require transplants and approximately 7000 patients die each year while waiting for a transplant. In the United States, patients need to wait 2.5 years for a kidney transplant, during which approximately 16 per cent of them experience severe health deterioration or death.
Asia-Pacific is projected to grow the fastest during the forecast period in the tissue regeneration technology market.
Asia-Pacific is projected to grow the fastest during the forecast period in the tissue regeneration technology market. Asia-Pacific is the fastest-growing region because it has a large patient population and its healthcare expenses are increasing while its healthcare systems are developing. The market in this region is experiencing growth because of three factors, which include people becoming more aware of regenerative medicine, medical tourism expansion and research activities in China and India
Unlock exclusive market insights—Download the Brochure now and dive deeper into the future of the Tissue Regeneration Technology Market.
Ready to lead the Tissue Regeneration Technology Market?
Discover the regional trends and growth factors shaping the industry. We’re here to assist with expert, personalized data.
Call +1 303 800 4326 or Send us a message for a personalized consultation.
Top 10 Trends in the Tissue Regeneration Technology Market
- Advancements in 3D bioprinting for tissue and organ fabrication
- Integration of stem cell therapies with regenerative scaffolds
- Personalised and patient-specific regenerative treatments
- Use of biomaterials and smart scaffolds for enhanced tissue repair
- Growth of organoids and lab-grown tissue models
- Increasing adoption of regenerative therapies in chronic disease management
- Expansion of regenerative medicine in cosmetic and dermatology applications
- AI and machine learning applications in tissue engineering and drug testing
- Rising collaborations between biotech firms, hospitals, and research institutions
- Regulatory support and accelerated approval pathways for regenerative products
1. Advancements in 3D bioprinting
3D bioprinting is a technique that allows for the creation of intricate structures of tissues and organ-like structures. This technique is used for creating tissues by layering them, thus allowing for better modelling, drug testing, and even a potential alternative for organ transplants.
2. Integration of stem cell therapies with scaffolds
The combination of stem cells and scaffolds is a technique that allows for better repair and regeneration of tissues. This is done by providing a scaffold for tissues, thus allowing for better repair by stem cells.
3. Personalised regenerative treatments
Personalised regenerative treatments involve a combination of therapies that are tailored to suit a person's needs. These therapies are more beneficial since they allow for better recovery, thus minimising the risk of immune rejection.
4. Biomaterials and smart scaffolds
Biomaterials and smart scaffolds are a new class of materials that are used for creating tissues. These materials are beneficial since they allow for better repair of tissues, thus improving the overall functioning of tissues.
5. Organoids and lab-grown tissues
An organoid is a small, lab-grown replica of a human organ. These structures are beneficial since they allow for better modelling of tissues, thus creating a potential alternative for organ transplants.
Empower your strategic planning
Stay informed with the latest industry insights and market trends to identify new opportunities and drive growth in the anti-venom market. To explore more in-depth trends, insights, and forecasts, please refer to our detailed report.
Unlock exclusive market insights—Download the Brochure now and dive deeper into the future of the Tissue Regeneration Technology Market.
Top 20 Companies Leading the Tissue Regeneration Technology Market
- Zimmer Biomet Holdings, Inc.
- Medtronic plc
- Organogenesis Holdings Inc.
- Integra LifeSciences Holdings Corporation
- Stryker Corporation
- Smith & Nephew plc
- Baxter International Inc.
- Becton Dickinson and Company (BD)
- B. Braun SE
- Tissue Regenix Group plc
- MiMedx Group, Inc.
- Athersys, Inc.
- RTI Surgical, Inc.
- ReproCell, Inc.
- Johnson & Johnson Services, Inc.
- Abbott/AbbVie (Allergan)
- NuVasive, Inc.
- 3M Company
- Cook Group Inc.
- CollPlant Biotechnologies Ltd.
1. Zimmer Biomet Holdings, Inc.
Headquarters: Warsaw, Indiana, United States.
Zimmer Biomet operates as a United States medical device manufacturer that started its business operations in 1927 and expects to achieve revenue increases through its orthopaedic reconstructive and soft tissue repair product lines during 2024. The company sells its products in more than 40 countries, while its portfolio contains joint replacement systems, robotic surgical systems and materials used to regenerate tissue for wound and tissue restoration. The company made a strategic decision to develop surgical robotics systems, which would enable doctors to perform tissue operations with better accuracy, when it expanded its robotic surgical system collection in 2025.
2. Medtronic plc
Headquarters: Dublin, Ireland
Medtronic, which became operational in 1949, generated approximately USD 32.4 billion through its global business operations during 2024, making it one of the largest medical technology companies in the world. The company produces multiple medical devices and treatments that treat conditions in the cardiovascular and diabetes, neuroscience, and surgical markets, while some of its products help with tissue regeneration and repair through structural heart and spine technologies. Medtronic operates in more than 150 countries while it develops new products through its research on implantable devices and systems, which require minimal body entry.
3. Integra LifeSciences Holdings Corporation
Headquarters: Princeton, New Jersey, United States.
Integra operates as a worldwide manufacturer of medical devices, which focuses on regenerative technologies, advanced wound care solutions and surgical tools since its establishment in 1989. The company provides products that include artificial skin and dermal regeneration templates and neurosurgical devices that enable tissue restoration and healing processes. The company established itself as a market leader in clinical regeneration solutions through its artificial skin products, which hospitals use to treat severe burns and complex wounds in all major international healthcare markets where it operates.
4. Organogenesis Holdings Inc.
Headquarters: Canton, Massachusetts, United States
Organogenesis has developed its regenerative medicine research since the mid-1980s to create advanced wound care products, surgical products and sports medicine products. The company experienced a revenue increase of approximately USD 563 million in 2025 because its advanced wound care products, Apligraf, Dermagraft and placental allografts enabled hospitals to treat complicated wounds and fix body tissues. The company runs its business throughout the United States while expanding its next-generation regenerative solutions for international markets.
5. Stryker Corporation
Headquarters: Portage, Michigan, United States.
Stryker began operations in 1941 and now stands as a top medical technology company that sells various products ranging from orthopaedic implants to surgical instruments and neurotechnology solutions that aid tissue reconstruction. Stryker generates its revenue growth from orthopaedic and robotic systems that enable tissue regeneration, even though its 2024 revenue report includes multiple medtech market segments. Stryker operates in more than 75 countries and ranks among the world’s leading medical device manufacturers who drive advancements in regenerative medical treatments.
Are you ready to discover more about the Tissue Regeneration Technology Market?
The report provides an in-depth analysis of the leading companies operating in the global tissue regeneration technology market. It includes a comparative assessment based on their product portfolios, business overviews, geographical footprint, strategic initiatives, market segment share, and SWOT analysis. Each company is profiled using a standardised format that includes:
Unlock exclusive market insights—Download the Brochure now and dive deeper into the future of the Tissue Regeneration Technology Market.
Company Profile
- Microsoft Corporation
- Business Overview
- Company Snapshot
- Products Overview
- Company Market Share Analysis
- Company Coverage Portfolio
- Financial Analysis
- Recent Developments
- Merger and Acquisitions
- SWOT Analysis
- Medtronic plc
- Organogenesis Holdings Inc.
- Integra LifeSciences Holdings Corporation
- Stryker Corporation
- Smith & Nephew plc
- Baxter International Inc.
- Becton Dickinson and Company (BD)
- B. Braun SE
- Tissue Regenix Group plc
- MiMedx Group, Inc.
- Athersys, Inc.
- RTI Surgical, Inc.
- ReproCell, Inc.
- Johnson & Johnson Services, Inc.
- Abbott/AbbVie (Allergan)
- NuVasive, Inc.
- 3M Company
- Cook Group Inc.
- CollPlant Biotechnologies Ltd.
Our Reports
https://www.sphericalinsights.com/reports/europe-anti-aging-supplements-market
https://www.sphericalinsights.com/reports/europe-ophthalmic-drugs-market
https://www.sphericalinsights.com/reports/europe-methanol-market
https://www.sphericalinsights.com/reports/germany-asphalt-pavers-market
https://www.sphericalinsights.com/reports/france-fertility-services-market
Conclusion
The global tissue regeneration technology market size is expected to grow at a compound annual growth rate (CAGR) of 15.2%, from USD 17.87 billion in 2024 to USD 73.45 billion by 2035. Global market expansion is hindered in organ transplantation, surged in chronic diseases & ageing population, and technological advancements. North America leads the tissue regeneration technology market because its advanced healthcare facilities, high healthcare spending, and major pharmaceutical and biotech companies create an advantageous environment. Asia-Pacific is the fastest-growing region because it has a large patient population and its healthcare expenses are increasing while its healthcare systems are developing.
About the Spherical Insights & Consulting
Spherical Insights & Consulting is a market research and consulting firm which provides actionable market research study, quantitative forecasting and trends analysis provides forward-looking insight especially designed for decision makers and aids ROI.
Which is catering to different industry such as financial sectors, industrial sectors, government organizations, universities, non-profits and corporations. The company's mission is to work with businesses to achieve business objectives and maintain strategic improvements.
CONTACT US:
For More Information on Your Target Market, Please Contact Us Below:
Phone: +1 303 800 4326 (the U.S.)
Phone: +91 90289 24100 (APAC)
Email: inquiry@sphericalinsights.com, sales@sphericalinsights.com
Contact Us: https://www.sphericalinsights.com/contact-us
Need help to buy this report?